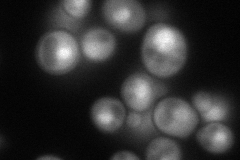
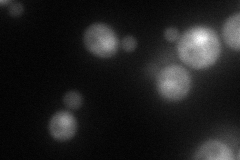
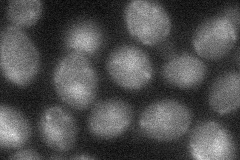
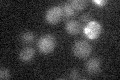

View description
Integral subunit of SAGA histone acetyltransferase complex, regulates transcription of a subset of SAGA-regulated genes, required for the Ubp8p association with SAGA and for H2B deubiquitylation
Localization:
Intensity:
Fold change:
Significance:
-
C’ GFP library in SD

below threshold13.23 -
N' NOP1pr-GFP in SD
cytosol,nucleus88.7199 -
N' TEF2pr-mCherry in SD
nucleus69.264 -
N' NATIVEpr-GFP in SD

nucleus28.0176 -
N' TEF2pr-VC and Cyto-VN in SD
nucleus28.4681 -
C’ GFP library in SD+DTT

cytosol16.161.22No -
C’ GFP library in SD+H2O2

cytosol13.541.02No -
C’ GFP library in Starvation Media
cytosol13.541.02No -
C’ GFP library on the background of Pup2-DaMP

below threshold -
C’ GFP library on the background of CCT mutant

below threshold11.87790.897532No
